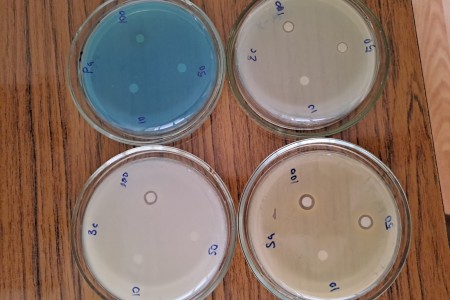

Научные сотрудники НИИ клинической и экспериментальной лимфологии – филиал ИЦиГ СО РАН разработали прототип лекарственного средства на основе антибактериального пептидомиметика и инертного полимерного геля для лечения инфекционных поражений кожи и подкожной клетчатки. Средство эффективно уничтожает болезнетворные бактерии и способствует более быстрому заживлению ран.
От 0,3 до 1,6 % пожилых людей в России страдают от незаживающих поражений кожи – трофических язв. Число таких пациентов неуклонно растет и не только в этой возрастной группе. Так, проблемы, связанные с появлением трофических язв. имеют 19% пациентов с сахарным диабетом. Лечение таких пациентов часто осложняется проблемой устойчивости болезнетворных бактерий, попадающих в рану, к антибактериальной терапии. В 2020 г. Всемирная организация здравоохранения назвала проблему антибиотикорезистентности одной из 10 глобальных угроз здоровью населения планеты.
Таким образом, назрела необходимость создания нового безопасного антибактериального и противогрибкового средства, которое будет эффективно уничтожать возбудителя, способствуя заживлению ран.

– Мы ввели в состав геля синтетический антимикробный пептидомиметик КАМП-1. Это антибактериальный компонент, к которому сложно развивается устойчивость микроорганизмов. Принцип действия антибактериального пептидомиметика состоит в том, что он налипает на мембрану бактерии и приводит к ее гибели. Антимикробный пептидомиметик эффективен в отношении различных возбудителей инфекций, включая грибки рода Сandida, – пояснил руководитель отдела экспериментальной фармакологии НИИКЭЛ, д.м.н Павел Геннадьевич Мадонов.
Исследования показали: гель с пептидомиметиком обеспечивает антибактериальную санацию на поверхности раны и в прилегающих слоях дермы без значимого всасывания в системный кровоток. Таким образом препарат не проявляет высокой токсичности.
Гель с антимикробным пептидомиметиком может быть востребован в области хирургии и при лечении инфекционных поражений кожи. Разрабатываемый препарат будет эффективен для пациентов с трофическими язвами, длительно незаживающими ранами, а также с огнестрельными и осколочными ранами.
В настоящее время проверена антимикробная активность пептидомиметика КАМП-1. В ближайшие годы планируется начать сначала доклинические испытания на животных, а затем – клинические исследования. Вывод нового препарата в производство, по предварительным прогнозам, возможен в 2030 году.
Разработка включена в государственное задание молодежной лаборатории в составе СибБИОНОЦ.
В ноябре проект был представлен на всероссийской Ярмарке продуктовых разработок в сфере медицины и здравоохранения.